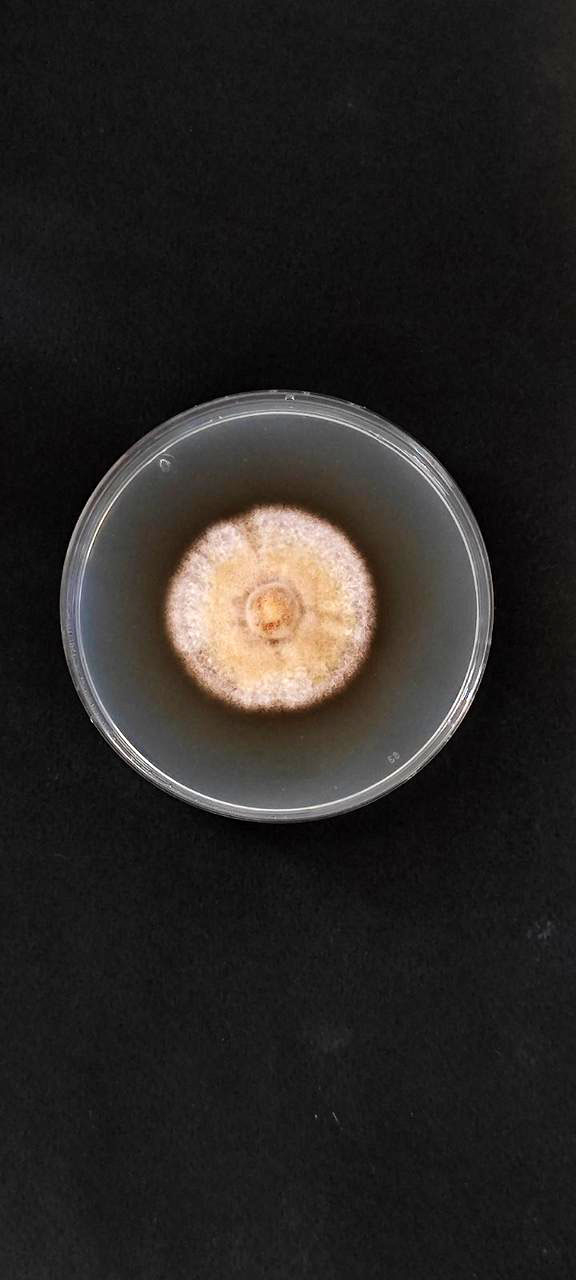

IMPROVITO - Ε.Ε.3
Εφαρμογές βιολογικών παραγόντων για αντιμετώπιση παθογόνων ΙΝΑ
Η Ε.Ε.3 αποσκοπεί στην αποτύπωση του μικροβιώματος του ριζικού συστήματος υγιών πρέμνων από αμπελώνες της περιοχής Νεμέας με στόχο την επιλογή μικροβιακών οργανισμών που ελέγχθηκαν για τη δυνατότητα βιολογικού ελέγχου των ασθενειών του ξύλου και την προαγωγή της ανάπτυξης των φυτών. Η αποτύπωση του μικροβιώματος έγινε με αλληλούχιση νέας γενιάς (NGS), ενώ οι μικροβιακοί οργανισμοί απομονώθηκαν από τις ρίζες σε τεχνητά θρεπτικά υποστρώματα. Μετά από την απομόνωσή του έγινε μία αρχική διερεύνηση της αποτελεσματικότητάς τους να ελέγχουν παθογόνα ΙΝΑ in vitro. Για τους πιο αποτελεσματικούς από αυτούς έγινε ταυτοποίηση με τη χρήση κατάλληλων μοριακών μεθοδολογιών και ακολούθησε η διερεύνηση του μηχανισμού δράσης τους και η αξιολόγηση της δράσης με εφαρμογές στο ριζικό σύστημα των φυτών, τεχνητές μολύνσεις με τα παθογόνα στο εργαστήριο και το φυτώριο και εκτίμηση της έντασης προσβολής από τα παθογόνα με qPCR. Την εύρεση αποτελεσματικών βιολογικών παραγόντων με δυνατότητα καταστολής των παθογόνων ΙΝΑ. Οι βιολογικοί παράγοντες με αποδεδειγμένη κατασταλτική δράση θα μπορούν να εφαρμοστούν κατά την παραγωγή του πολλαπλασιαστικού υλικού ή και στον αγρό, μεμονωμένα ή σε συνδυασμό με κατάλληλα χημικά σκευάσματα, ως παράγοντες αντιμετώπισης των παθογόνων ΙΝΑ. Με την εύρεση αποτελεσματικών βιολογικών παραγόντων, τα φυτά που καλλιεργούνται στο φυτώριο θα έχουν μεγαλύτερη ευρωστία, μικρότερη πιθανότητα προσβολής από παθογόνα ΙΝΑ. Επίσης το τελικό προϊόν με το οποίο τροφοδοτεί το φυτώριο την αγορά θα είναι εμβολιασμένο με τον βιολογικό παράγοντα (μέσο των φυτών σε κύπελλα) και οι αμπελουργοί θα έχουν φυτά ποιο εύρωστα και υγιή.